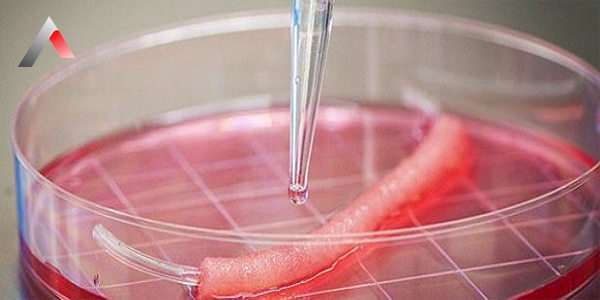
Penis_Kal__nla__t__rmada_Doku_Transferi_757cb7e9.webp

Penis uzatma ameliyatı, penisin boyutunu ve uzunluğunu artırmak için yapılan cerrahi bir işlemdir. Ameliyat sırasında, penisin tabanındaki bağlar kesilerek penisin serbestçe uzaması sağlanır. Bu işlem sonucunda, penisin sarkık durumdaki uzunluğu ortalama 2-3 cm kadar artar. Ancak, ereksiyon halindeki penisin boyutunda herhangi bir değişiklik olmaz.
Penis uzatma ameliyatı, genellikle penis boyutundan memnun olmayan erkeklerde yapılır. Ayrıca, penisin aşırı küçük olması durumunda da bu ameliyat uygulanabilir.
Penis uzatma ameliyatı, genel anestezi altında yapılır ve yaklaşık 1-2 saat sürer. Ameliyattan sonra hastanın bir gece hastanede kalması gerekebilir.
Penis uzatma ameliyatı, penisin boyutunu ve görünümünü iyileştirmek için etkili bir yöntemdir. Ancak, bu ameliyatın riskleri ve komplikasyonları hakkında bilgi sahibi olmak önemlidir.
Penis uzatma ameliyatı hakkında daha fazla bilgi için bir doktorumuz ile görüşmeniz tavsiye edilir.

Penis kalınlaştırma ameliyatı, penisin çevresini büyütmek için yapılan cerrahi bir işlemdir. Ameliyat sırasında, penisin gövdesine yağ, doku veya silikon implantlar enjekte edilir veya penisin derisine dolgu yapılır.
Penis kalınlaştırma ameliyatı, genellikle penis boyutundan memnun olmayan erkeklerde yapılır. Ayrıca, penisin aşırı ince olması durumunda da bu ameliyat uygulanabilir.
Penis kalınlaştırma ameliyatı, genel anestezi altında yapılır ve yaklaşık 1-2 saat sürer. Ameliyattan sonra hastanın bir gece hastanede kalması gerekebilir.
Penis kalınlaştırma ameliyatı, penisin boyutunu ve görünümünü iyileştirmek için etkili bir yöntemdir. Ancak, bu ameliyatın riskleri ve komplikasyonları hakkında bilgi sahibi olmak önemlidir.
Penis kalınlaştırma ameliyatı hakkında daha fazla bilgi için bir doktorumuzla ile görüşmeniz tavsiye edilir.
İşte penis kalınlaştırma ameliyatı için kullanılan bazı yöntemler:
Penis kalınlaştırma ameliyatı için en uygun yöntem, hastanın bireysel ihtiyaçlarına göre belirlenir.

Penis kalınlaştırmada yağ enjeksiyonu, penisin çevresini büyütmek için kullanılan bir cerrahi yöntemdir. Bu yöntemde, hastanın vücudunun başka bir yerinden alınan yağ, penisin gövdesine enjekte edilir.
Penis kalınlaştırmada yağ enjeksiyonu, en yaygın kullanılan penis kalınlaştırma yöntemidir. Bu yöntemin avantajları arasında, nispeten düşük riskli olması ve hızlı iyileşme süresi olması yer alır.
Penis kalınlaştırmada yağ enjeksiyonu, aşağıdaki adımlarla yapılır:
Penis kalınlaştırmada yağ enjeksiyonunun riskleri arasında, enfeksiyon, kanama ve yağ hücrelerinin erimesi yer alır. Yağ hücrelerinin erimesi, penisin kalınlığında azalma ile sonuçlanabilir.
Penis kalınlaştırmada yağ enjeksiyonu, penisin boyutunu ve görünümünü iyileştirmek için etkili bir yöntemdir. Ancak, bu yöntemin riskleri ve komplikasyonları hakkında bilgi sahibi olmak önemlidir.
Penis kalınlaştırmada yağ enjeksiyonu hakkında daha fazla bilgi için bir ürolog ile görüşmeniz tavsiye edilir.

Penis kalınlaştırmada doku transferi, penisin çevresini büyütmek için kullanılan bir cerrahi yöntemdir. Bu yöntemde, penisin gövdesine başka bir bölgeden alınan doku parçaları transfer edilir.
Penis kalınlaştırmada doku transferi, daha kalıcı bir kalınlaşma sağlar. Bu yöntem, genellikle yağ enjeksiyonunun başarısız olduğu veya yağ hücrelerinin erimesi nedeniyle yeterli kalınlaşma sağlanamadığı durumlarda uygulanır.
Penis kalınlaştırmada doku transferi, aşağıdaki adımlarla yapılır:
Penis kalınlaştırmada doku transferinin riskleri arasında, enfeksiyon, kanama, yara iyileşme sorunları ve duyu kaybı yer alır.
Penis kalınlaştırmada doku transferi, penisin boyutunu ve görünümünü iyileştirmek için etkili bir yöntemdir. Ancak, bu yöntemin riskleri ve komplikasyonları hakkında bilgi sahibi olmak önemlidir.
Penis kalınlaştırmada doku transferi hakkında daha fazla bilgi için bir ürolog ile görüşmeniz tavsiye edilir.
İşte penis kalınlaştırmada doku transferi için kullanılan bazı dokular:
Penis kalınlaştırmada doku transferi için en uygun doku, hastanın bireysel ihtiyaçlarına göre belirlenir.
Penis Kalınlaştırmada Silikon İmplantlar
Penis kalınlaştırmada silikon implantlar, penisin çevresini büyütmek için kullanılan bir cerrahi yöntemdir. Bu yöntemde, penisin gövdesine silikon implantlar yerleştirilir.
Penis kalınlaştırmada silikon implantlar, en kalıcı kalınlaşma sağlar. Bu yöntem, genellikle diğer yöntemlerle yeterli kalınlaşma sağlanamadığı durumlarda uygulanır.
Penis kalınlaştırmada silikon implantlar, aşağıdaki adımlarla yapılır:
Penisin gövdesine, küçük bir kesik açılarak implantlar yerleştirilir.
İmplantlar, penisin gövdesine yerleştirilir.
Yaralar kapatılır.
Penis kalınlaştırmada silikon implantların riskleri arasında, enfeksiyon, kanama, implantların hareket etmesi veya kayması ve duyu kaybı yer alır.
Penis kalınlaştırmada silikon implantlar, penisin boyutunu ve görünümünü iyileştirmek için etkili bir yöntemdir. Ancak, bu yöntemin riskleri ve komplikasyonları hakkında bilgi sahibi olmak önemlidir.
Penis kalınlaştırmada silikon implantlar hakkında daha fazla bilgi için bir ürolog ile görüşmeniz tavsiye edilir.
İşte penis kalınlaştırmada silikon implantlar için kullanılan bazı implantlar:
Penis kalınlaştırmada silikon implantlar için en uygun implant, hastanın bireysel ihtiyaçlarına göre belirlenir.
Penis kalınlaştırmada dolgu işlemi, penisin gövdesi içine dolgu maddesi enjekte edilerek penisin kalınlaştırılması işlemidir. Bu işlem, penisi kalınlaştırmak isteyen erkekler için popüler bir seçenektir.
Dolgu maddesi olarak, genellikle hyalüronik asit veya yağ kullanılır. Hyaluronik asit, ciltte doğal olarak bulunan bir maddedir ve cildi nemlendirir. Yağ ise hastanın kendi vücudundan alınan yağdır.
Dolgu işlemi, lokal anestezi altında yapılır. Penisin gövdesi, ince bir iğne ile delinir ve dolgu maddesi enjekte edilir. İşlem genellikle 30-45 dakika sürer.
Dolgu işleminin sonuçları hemen görülür ve 2-3 yıl sürer. Dolgu maddesi zamanla emildiği için, işlemin tekrarlanması gerekebilir.
Dolgu işleminin riskleri arasında, enfeksiyon, kanama ve alerji yer alır. Ancak bu riskler oldukça nadirdir.
Dolgu işlemi, penisini kalınlaştırmak isteyen erkekler için güvenli ve etkili bir seçenektir. Ancak, işlemin riskleri hakkında doktorunuzla konuşmanız önemlidir.
Dolgu işleminin bazı avantajları şunlardır:

Bu içerik, A Life Sağlık Grubu Genel Cerrahi birimi uzmanları tarafından tıbbi literatür ve güncel cerrahi protokoller ışığında incelenmiş ve onaylanmıştır.
Son Güncelleme: 6 Kasım 2025 14:05
Yayınlanma Tarihi: 25 Nisan 2024 10:12

Fiyatlarımız ve Uygulama Yöntemlerimiz Hakkında Hızlı Bilgi Alma Formumuzu Kullanabilirsiniz.
7/24 tüm soru ve sorunlarınız için buradayız.